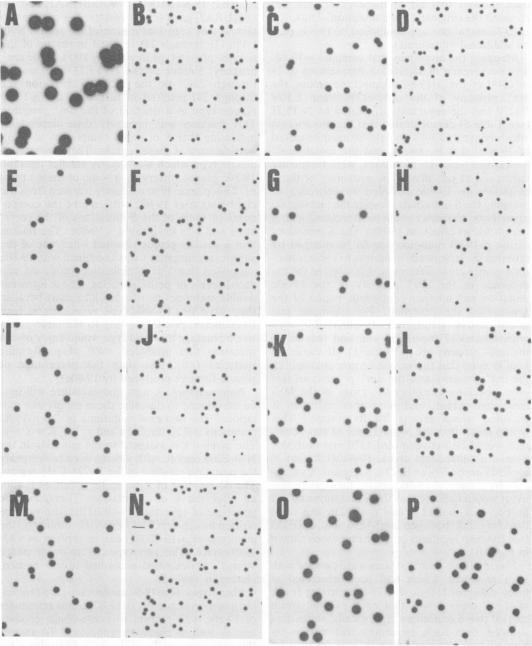
https://cdn.ncbi.nlm.nih.gov/pmc/blobs/eb0a/256166/dd02a5519098/jvirol00155-0291-a.jpg

噬菌体T4衣壳长度决定的遗传学研究。I. 影响衣壳长度的基因23突变的第二位点回复突变体的分离与部分特性分析。
Genetic studies on capsid-length determination in bacteriophage T4. I. Isolation and partial characterization of second-site revertants of a gene 23 mutation affecting capsid length.
作者信息
Doherty D H
出版信息
J Virol. 1982 Aug;43(2):641-54. doi: 10.1128/JVI.43.2.641-654.1982.
The T4 mutation ptg19-80 affects the mechanism of capsid-length determination. It is located in gene 23, which encodes the major structural protein of the capsid. The mutation results in the production of abnormal-length capsids in high frequencies. This paper describes the isolation and partial characterization of second-site revertants of ptg19-80. In the course of their analysis, it was discovered that ptg19-80 is itself a double mutation consisting of a gene 23 mutation (ptg19-80c), which causes the morphogenetic defect, and a suppressor mutation located near the lysozyme gene. Phenotypic characterization of nine pseudo-wild-type revertants of this double-mutation revealed that these revertants all produced lower frequencies of abnormal capsids than did ptg19-80. Seven of these revertants were shown to contain two suppressor mutations, one mapping in or near gene 22 and done mapping in or near gene 24. Both mutations were required for suppression. These suppressors displayed no discernible phenotype in the absence of ptg19-80c.
T4突变体ptg19 - 80影响衣壳长度确定机制。它位于基因23中,该基因编码衣壳的主要结构蛋白。该突变导致高频率产生异常长度衣壳。本文描述了ptg19 - 80的二次位点回复突变体的分离及部分特征。在分析过程中,发现ptg19 - 80本身是一个双重突变,由一个导致形态发生缺陷的基因23突变(ptg19 - 80c)和一个位于溶菌酶基因附近的抑制突变组成。对这个双重突变的九个假野生型回复突变体的表型特征分析表明,这些回复突变体产生异常衣壳的频率均低于ptg19 - 80。其中七个回复突变体被证明含有两个抑制突变,一个位于基因22内或附近,另一个位于基因24内或附近。两个突变都是抑制所必需的。在没有ptg19 - 80c的情况下,这些抑制突变没有明显的表型。